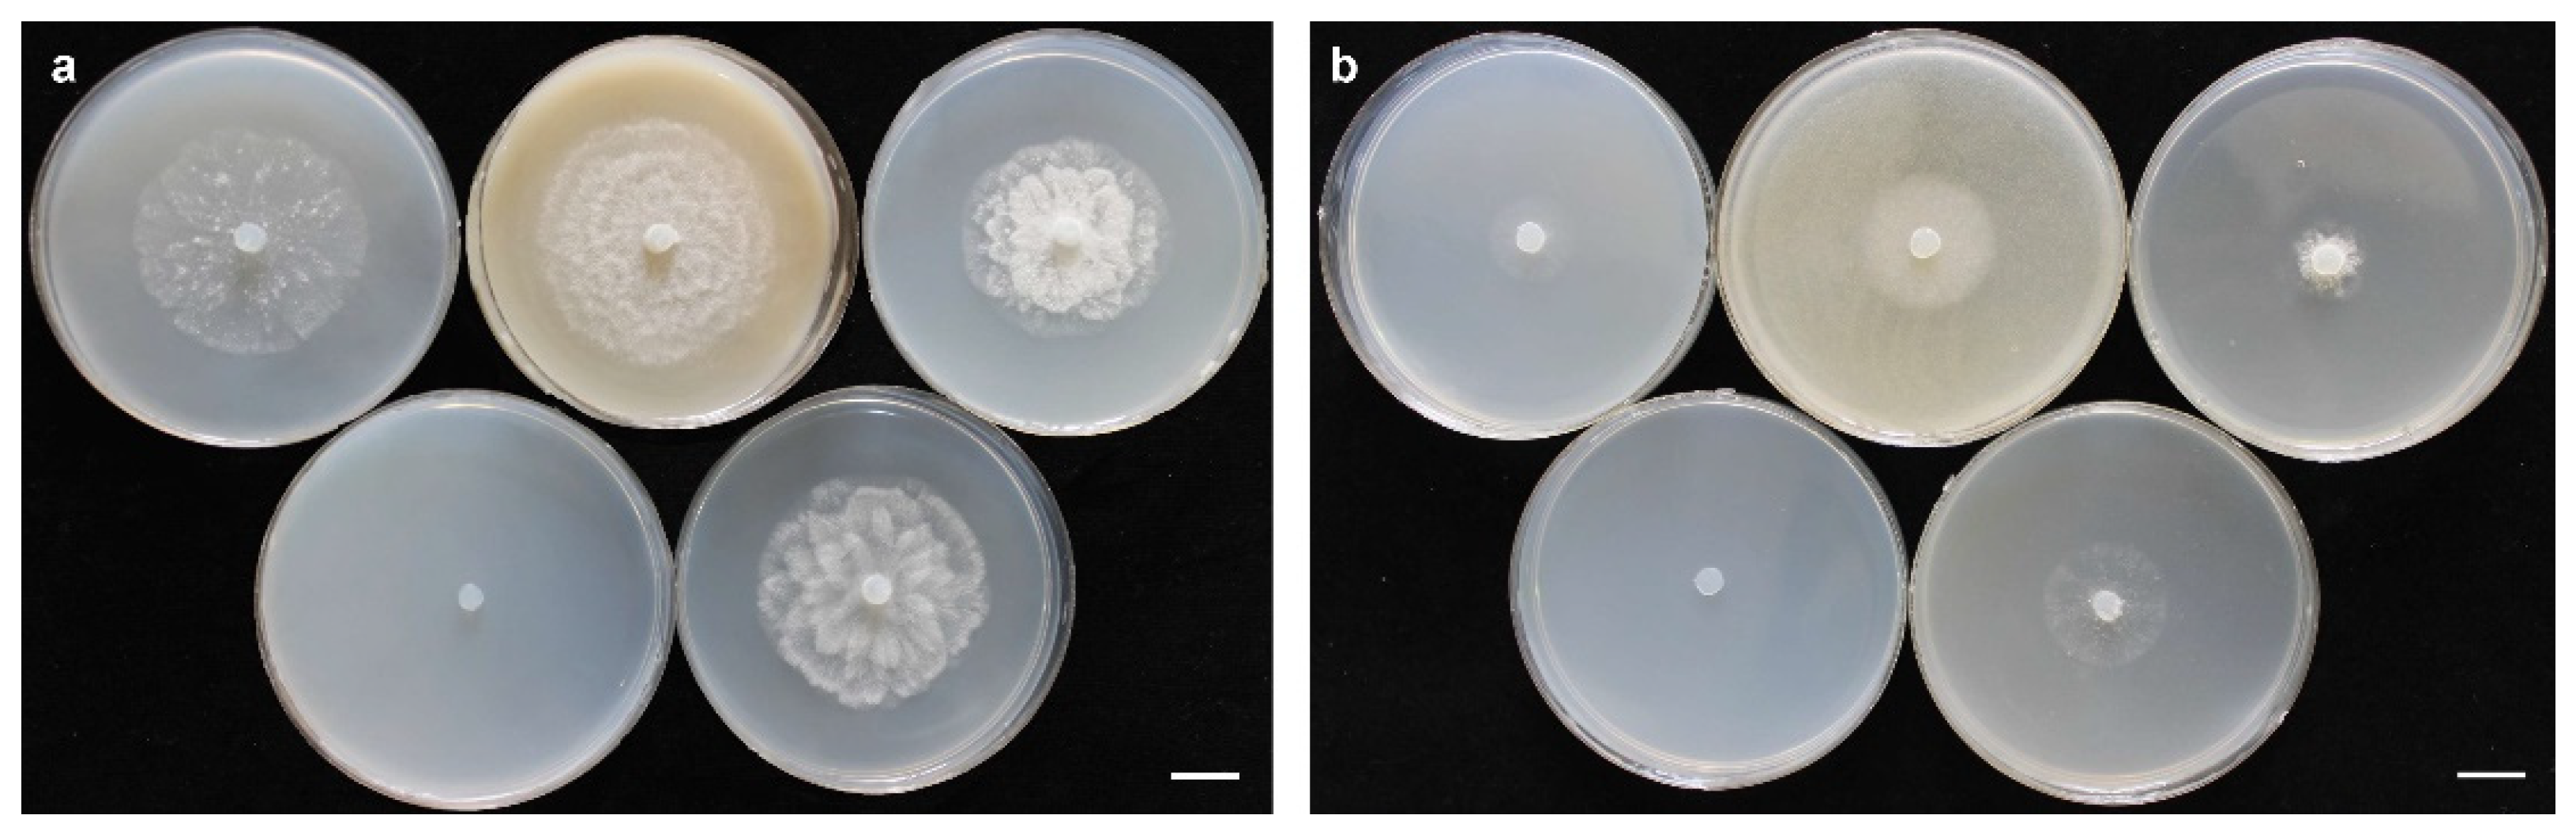
Jof 10 00405 g004 Jof 10 00405 g004

Pythium banihashemianum sp. nov. and Globisporangium izadpanahii sp. nov.: Two New Oomycete Species from Rice Paddies in Iran
Abstract
1. Introduction
2. Materials and Methods
2.1. Isolation
2.2. Morphological Characterization
2.3. DNA Extraction, PCR, Sequencing, and Phylogenetic Analyses
2.4. Pathogenicity
3. Results
3.1. Morphology of Isolates of Pythium s.l.
3.2. Phylogenetic Analyses


3.3. Pathogenicity

3.4. Taxonomy

4. Discussion
5. Conclusions
Supplementary Materials
Author Contributions
Funding
Institutional Review Board Statement
Informed Consent Statement
Data Availability Statement
Acknowledgments
Conflicts of Interest
References
- Hyde, K.D.; Nilsson, H.R.; Alias, S.A.; Ariuawansa, H.A.; Blair, J.E.; Cai, L.; de Cock, A.W.A.M.; Dissanayake, A.J.; Glockling, S.L.; Goonasekara, I.D.; et al. One stop shop: Backbones trees for important phytopathogenic genera: I (2014). Fungal Divers. 2014, 67, 21–125. [Google Scholar] [CrossRef]
- Van der Plaäts-Niterink, A.J. Monograph of the genus Pythium. Stud. Mycol. 1981, 21, 1–198. [Google Scholar]
- Czeczuga, B.; Mazalska, B.; Godlewska, A.; Muszynska, E. Aquatic fungi growing on dead fragments of submerged plants. J. Limnol. 2005, 35, 283–297. [Google Scholar] [CrossRef]
- Kawamura, Y.; Yokoo, K.; Tojo, M.; Hishiike, M. Distribution of Pythium porphyrae, the causal agent of red rot disease of Porphyrae spp., in the Ariake sea, Japan. Plant Dis. 2005, 89, 1041–1047. [Google Scholar] [CrossRef] [PubMed]
- Hwang, E.K.; Park, C.S.; Kakinuma, M. Physicochemical responses of Pythium porphyrae (Oomycota), the causative organism of red rot disease in Porphyra to acidification. Aquac. Res. 2009, 40, 1777–1784. [Google Scholar] [CrossRef]
- Li, W.; Zhang, T.; Tang, X.; Wang, B. Oomycetes and fungi: Important parasites on marine algae. Acta Oceanol. Sin. 2010, 29, 74–81. [Google Scholar] [CrossRef]
- Weiland, J.E.; Beck, B.R.; Davis, A. Pathogenicity and virulence of Pythium species obtained from forest nursery soils on Douglas-Fir seedlings. Plant Dis. 2012, 97, 744–748. [Google Scholar] [CrossRef] [PubMed]
- Ho, H.H. The genus Pythium in mainland China. Mycosystemata 2013, 32, 20–44. [Google Scholar]
- Elad, Y.; Lifshitz, R.; Baker, R. Enzymatic activity of the mycoparasite Pythium nunn during interaction with host and non-host fungi. Physiol. Plant Pathol. 1985, 27, 131–148. [Google Scholar] [CrossRef]
- Hockenhull, J.; Jensen, D.F.; Yudiarti, T. The use of Pythium periplocum to control damping-off of cucumber seedlings caused by Pythium aphanidermatum. In Biological Control of Plant Diseases-Progress and Challenges for the Future; Tjamos, E.C., Papavizas, G.C., Cook, R.J., Eds.; Springer: New York, NY, USA, 1992; pp. 203–206. [Google Scholar]
- Morajelo, E.; Clemente, A.; Descals, E.; Belbahri, L.; Calmin, G.; Lefort, F.; Spies, C.F.J.; McLeod, A. Pythium recalcitrans sp. nov. revealed by multigene phylogenetic analysis. Mycologia 2008, 100, 310–319. [Google Scholar]
- Kobayashi, S.; Uzuhashi, S.; Tojo, M.; Kakishima, M. Characterization of Pythium nunn newly recorded in Japan and its antagonistic activity against P. ultimum var. ultimum. J. Gen. Plant Pathol. 2010, 76, 278–283. [Google Scholar] [CrossRef]
- Horner, N.R.; Grenville-Bridge, L.J.; van West, P. The oomycete Pythium oligandrum expresses putative effectors during mycoparasitism of Phytophthora infestans and is amenable to transformation. Fungal Biol. 2012, 116, 24–41. [Google Scholar] [CrossRef] [PubMed]
- Bahramisharif, A.; Lamprecht, S.; Calitz, F.; McLeod, A. Suppression of Pythium and Phytophthora damping-off of Rooibos by compost and a combination of compost and nonpathogenic Pythium taxa. Plant Dis. 2013, 97, 1605–1610. [Google Scholar] [CrossRef] [PubMed]
- Mostowfizadeh-Ghalamfarsa, R. The current status of Pythium species in Iran: Challenges in taxonomy. Mycol. Iran. 2015, 2, 79–87. [Google Scholar]
- Lévesque, C.A.; de Cock, A.W.A.M. Molecular phylogeny and taxonomy of the genus Pythium. Mycol. Res. 2004, 108, 1363–1383. [Google Scholar] [CrossRef] [PubMed]
- Uzuhashi, S.; Tojo, M.; Kakishima, M. Phylogeny of the genus Pythium and description of new genera. Mycoscience 2010, 51, 337–365. [Google Scholar] [CrossRef]
- Baten, M.A.; Asano, T.; Motohashi, K.; Ishiguro, Y.; Rahman, M.Z.; Inaba, S.; Suga, H.; Kageyama, K. Phylogenetic relationships among Phytopythium species, and re-evaluation of Phytopythium fagopyri comb. nov., recovered from damped-off buckwheat seedlings in Japan. Mycol. Prog. 2014, 13, 1145–1156. [Google Scholar] [CrossRef]
- Nguyen, H.D.T.; Dodge, A.; Dadej, K.; Rintoul, T.L.; Ponomareva, E.; Martin, F.N.; de Cock, A.W.A.M.; Lévesque, C.A.; Redhead, S.A.; Spies, C.F.J. Whole genome sequencing and phylogenomic analysis show support for the splitting of genus Pythium. Mycologia 2022, 114, 501–515. [Google Scholar] [CrossRef] [PubMed]
- Martin, F.N. Phylogenetic relationships among some Pythium species inferred from sequence analysis of the mitochondrially encoded cytochrome oxidase II gene. Mycologia 2000, 95, 269–284. [Google Scholar] [CrossRef]
- de Cock, A.W.A.M.; Lèvesque, C.A. New species of Pythium and Phytophthora. Stud. Mycol. 2004, 50, 481–487. [Google Scholar]
- Bala, K.; Robideau, G.P.; Desaulniers, N.; de Cock, A.W.A.M.; Levesque, C.A. Taxonomy, DNA barcoding and phylogeny of three new species of Pythium from Canada. Persoonia 2010, 25, 22–31. [Google Scholar] [CrossRef] [PubMed]
- Robideau, G.P.; de Cock, A.W.A.M.; Coffey, M.D.; Volgmayr, H.; Brouwer, H.; Bala, K.; Chitty, D.W.; Desaulniers, N.; Eggertson, Q.A.; Gachon, C.M.; et al. DNA barcoding of oomycetes with cytochrome c oxidase subunit I and internal transcribed spacer. Mol. Ecol. Resour. 2011, 11, 1002–1011. [Google Scholar] [CrossRef] [PubMed]
- Villa, N.O.; Kageyama, K.; Asano, T.; Suga, H. Phylogenetic relationships of Pythium and Phytophthora species based on ITS rDNA, cytochrome oxidase II and β-tubuline gene sequences. Mycologia 2006, 98, 410–422. [Google Scholar] [PubMed]
- Rahman, M.Z.; Abdelzaher, H.M.A.; Mingzhu, L.; Motohashi, K.; Suga, H.; Kageyama, K. Pythium rishiriense sp. nov. from water and P. alternatum sp. nov. from soil, two new species from Japan. FEMS Microbiol. Lett. 2015, 362, fnv086. [Google Scholar] [CrossRef] [PubMed]
- Uzuhashi, S.; Okada, G.; Ohkuma, M. Four new Pythium species form aquatic environments in Japan. Antonie Leewenhoek 2015, 107, 375–391. [Google Scholar] [CrossRef] [PubMed]
- Uzuhashi, S.; Hata, K.; Matsuura, S.; Tojo, M. Globisporangium oryzicola sp. nov., causing poor seedling establishment of directly seeded rice. Antonie Leeuwenhoek 2017, 110, 543–552. [Google Scholar] [CrossRef] [PubMed]
- Abad, Z.G.; Burgess, T.; Bourret, K.; Cacciola, S.O.; Scanu, B.; Mathew, R.; Kasiborski, B.; Srivastava, S.; Kageyama, K.; Buienpfl, J.C.; et al. Phytophthora: Taxonomic and phylogenetic revision of the genus. Stud. Mycol. 2023, 106, 259–348. [Google Scholar] [CrossRef] [PubMed]
- Hendrix, F.F.; Campbell, W.A. Pythiums as plant pathogens. Annu. Rev. Phytopathol. 1973, 11, 77–98. [Google Scholar] [CrossRef]
- Jung, T.; Milenković, I.; Balci, Y.; Janoušek, J.; Kudláček, T.; Nagy, Z.Á.; Baharuddin, B.; Bakonyi, J.; Broders, K.D.; Cacciola, S.O.; et al. Worldwide forest surveys reveal forty-three new species in Phytophthora major Clade 2 with fundamental implications for the evolution and biogeography of the genus and global plant biosecurity. Stud. Mycol. 2024, 107, 251–388. [Google Scholar]
- Hsieh, H.J. An annotated list of Pythium in Taiwan. Bot. Bull. Acad. Sinica 1978, 19, 199–205. [Google Scholar]
- Ventura, F.; Watanabe, I.; Castillo, M.B.; De La Cruz, A. Involvement of nematodes in the soil sickness of a dryland rice-based cropping system. J. Soil Sci. Plant Nutr. 1981, 27, 305–315. [Google Scholar] [CrossRef]
- Chun, S.C. Etiology and Biological Control of Rice Seedling Disease in Water-Seeded Rice. Ph.D. Thesis, Department of Plant Pathology and Crop Physiology, Louisiana State University and Agricultural and Mechanical College, Baton Rouge, LA, USA, 1997. [Google Scholar]
- Chun, S.C.; Schneider, R.W. Sites of infection by Pythium species in rice seedlings and effects of plant age and water depth on disease development. Phytopathology 1998, 88, 1255–1261. [Google Scholar] [CrossRef][Green Version]
- Banaay, C.G.B.; Cuevas, V.C.; Vera Cruz, C.M. Trichoderma ghanense promotes plant growth and controls diseases caused by Pythium arrhenomanes in seedling of aerobic rice variety Apo. Phillip. Agric. Sci. 2012, 95, 175–184. [Google Scholar]
- Zhu, H. Utilization of Rice Bran by Pythium irregulare for Lipid Production. Master’s Thesis, Louisiana State University, Baton Roug, LA, USA, 2002. [Google Scholar]
- Eberle, M.A.; Rothroch, C.S.; Cartwright, R.D. Pythium species associated with rice stand establishment problems in Arkansas. AAES Res. Ser. 2007, 560, 57–63. [Google Scholar]
- Kreye, C.; Bouman, B.; Castañeda, A.R.; Lampayan, R.M.; Faronilo, J.E.; Lactaoen, A.T.; Fernandez, L. Possible causes of yield failure in tropical aerobic rice. Field Crop. Res. 2009, 111, 197–206. [Google Scholar] [CrossRef]
- Oliva, R.; Win, J.; Raffaele, S.; Boutemy, L.; Bozkurt, T.O.; Chaparro-Garcia, A.; Segretin, M.E.; Stam, R.; Schornack, S.; Cano, L.M.; et al. Recent developments in effector biology of filamentous plant pathogens. Cell. Microbiol. 2010, 12, 705–715. [Google Scholar] [CrossRef]
- Van Buyten, E.; Höfte, M. Pythium species from rice roots differ in virulence, host colonization and nutritional profile. BMC Plant Biol. 2013, 13, 203. [Google Scholar] [CrossRef]
- Toda, T.; Lwase, A.; Fuji, S.; Furuya, H. Widespread occurrence of Pythium arrhenomanes pathogenic to rice seedlings around Japanese rice fields. Plant Dis. 2015, 99, 1823–1831. [Google Scholar] [CrossRef]
- Salmaninezhad, F.; Mostowfizadeh-Ghalamfarsa, R. Three new Pythium species from rice paddy fields. Mycologia 2019, 111, 274–290. [Google Scholar] [CrossRef]
- Bolboli, Z.; Mostowfizadeh-Ghalamfarsa, R. Phylogenetic relationships and taxonomic characteristics of Pythium spp. isolates in cereal fields of Fars Province. Iran. J. Plant Pathol. 2015, 51, 471–492. [Google Scholar]
- Salmaninezhad, F.; Mostowfizadeh-Ghalamfarsa, R. Taxonomy, phylogeny and pathogenicity of Pythium species in rice paddy fields of Fars Province. Iran. J. Plant Pathol. 2017, 53, 31–53. [Google Scholar]
- Jeffers, S.N.; Martin, S.B. Comparison of two media selective for Phytophthora and Pythium species. Plant Dis. 1968, 70, 1035–1043. [Google Scholar]
- Tan, K.H. Soil Sampling, Preparation and Analysis; Marcel Dekker Inc.: New York, NY, USA, 1996; pp. 1–408. [Google Scholar]
- Mostowfizadeh-Ghalamfarsa, R.; Banihashemi, Z. Identification of soil Pythium species in Fars Province of Iran. Iran. J. Sci. Technol. 2005, 29, 79–87. [Google Scholar]
- Ho, H.H.; Chen, X.X.; Zeng, H.C.; Zheng, F.C. The occurrence distribution of Pythium species in Hanian south island of China. Bot. Stud. 2012, 53, 525–534. [Google Scholar]
- McLeod, A.; Botha, W.J.; Meitz, J.C.; Spies, C.F.J.; Tewoldemedhin, Y.T.; Mostert, L. Morphological and phylogenetic analysis of Pythium species in South Africa. Mycol. Res. 2009, 113, 933–951. [Google Scholar] [CrossRef] [PubMed]
- Schmitthenner, A.F. Isolation and identification methods for Phytophthora and Pythium. In Proceedings of the Woody Ornamental Disease Workshop, Colombia, MI, USA, 24–25 January 1973; University of Missouri: Colombia, MI, USA; p. 128. [Google Scholar]
- Mirsoleimani, Z.; Mostowfizadeh-Ghalamfarsa, R. Characterization of Phytophthora pistaciae, the causal agent of pistachio gummosis, based on host range, morphology and ribosomal genome. Phytopathol. Mediterr. 2013, 53, 501–506. [Google Scholar]
- Salmaninezhad, F.; Aloi, F.; Pane, A.; Mostowfizadeh-Ghalamfarsa, R.; Cacciola, S.O. Globisporangium coniferarum sp. nov., associated with conifers and Quercus spp. Fungal Syst. Evol. 2022, 10, 127–137. [Google Scholar] [CrossRef] [PubMed]
- Geneious. Available online: https://www.geneious.com (accessed on 6 February 2023).
- Altschul, S.F.W.; Gish, W.; Miller, E.W.; Meyers, E.W.; Lipman, D.J. Basic local alignment search tool. J. Mol. Biol. 1990, 215, 403–410. [Google Scholar] [CrossRef]
- Swofford, D. PAUP*: Phylogenetic Analysis Using Parsimony (*and Other Methods), Version 4.0 b10; Sinauer Associates: Sunderland, MA, USA, 2002. [Google Scholar]
- Ronquist, F.; Huelsenbeck, J.P. MrBayes 3: Bayesian phylogenetic inference under mixed models. Bioinformatics 2003, 19, 1572–1574. [Google Scholar] [CrossRef]
- Mishra, B.; Ploch, S.; Weiland, C.; Thines, M. The TrEase webserver: Inferring phylogenetic trees with ease. Mycol. Progr. 2023, 22, 84–90. [Google Scholar] [CrossRef]
- Tamura, K.; Stecher, G.; Kumar, S. MEGA 11: Molecular evolutionary genetics analysis version 11. Mol. Biol. Evol. 2021, 38, 3022–3027. [Google Scholar] [CrossRef]
- Banihashemi, Z. Study of pistachio gummosis in southern provinces of Iran. In Proceedings of the 9th Iranian Plant Protection Congress, Mashhad, Iran, 9–14 September 1989; p. 87. [Google Scholar]
- Afeck, U.; Sztejnberg, A.; Solel, Z. A rapid method for evaluating citrus seedlings for resistance to root rot caused by Phytophthora citrophthora. Plant Dis. 1990, 74, 66–68. [Google Scholar] [CrossRef]
- Dick, M.W. Keys to Pythium; University of Reading-School of Plant Sciences-Department of Botany: Reading, UK, 1990; p. 68. [Google Scholar]
- Salmaninezhad, F.; Mostowfizadeh-Ghalamfarsa, R. Phenotypic plasticity of the isolates assigned to Pythium plurisporium. Mycol. Iran. 2019, 6, 59–71. [Google Scholar]
- Abad, G.; Shew, H.D.; Grand, L.F.; Lucas, L.T. A new species of Pythium producing multiple oospores isolated from bentgrass in North Carolina. Mycologia 1995, 87, 896–901. [Google Scholar] [CrossRef]
- Paul, B.; Bala, K. A new species of Pythium with inflated sporangia and coiled antheridia, isolated from India. FEMS Microbiol. Lett. 2008, 282, 251–257. [Google Scholar] [CrossRef]
- de Cock, A.W.A.M.; Lodhi, A.M.; Rintoul, T.L.; Bala, K.; Robideau, G.P.; Abad, Z.G.; Coffey, M.D.; Shahzad, S.; Lévesque, C.A. Phytopythium: Molecular phylogeny and systematics. Persoonia 2015, 34, 25–39. [Google Scholar] [CrossRef]
| Species | Isolates | Date of Collection | Location | Longitude | Latitude | Matrix | GenBank Accession Number | |||
|---|---|---|---|---|---|---|---|---|---|---|
| ITS a | Btub b | cox1 c | cox2 d | |||||||
| Pythium banihashemianum sp. nov. | ||||||||||
| 068B1 *† | August 2015 | Kamfiruz | 30°16.934′ N | 052°19.155′ E | Rice root | KX228083 | KX228113 | OP321097 | KX228120 | |
| Th641 † | August 2015 | Persepolis | 29°59.008′ N | 052°49.513′ E | Rice soil | MK454538 | MK540656 | OP321102 | MK455863 | |
| Fk21 † | November 2015 | Fiurz Abad | 28°51.407′ N | 052°30.666′ E | Rice root | MK454539 | MK540655 | OP321098 | MK455862 | |
| 048S1 † | November 2015 | Ramjard | 30°02.780′ N | 052°49.513′ E | Rice root | N/A ‡‡ | N/A | N/A | N/A | |
| 038C3 † | November 2015 | Ramjard | 30°07.234′ N | 052°32.983′ E | Rice root | N/A | N/A | N/A | N/A | |
| 033B7 † | November 2015 | Ramjard | 30°07.274′ N | 052°32.946′ E | Rice soil | N/A | N/A | N/A | N/A | |
| 056S2 † | May 2014 | Kamfiruz | 30°11.909′ N | 052°27.779′ E | Rice soil | N/A | N/A | N/A | N/A | |
| K116-1 † | August 2015 | Kamfiruz | 30°11.017′ N | 052°27.900′ E | Rice soil | N/A | N/A | N/A | N/A | |
| Fs301 † | November 2015 | Fiurz Abad | 28°49.735′ N | 052°29.149′ E | Rice root | N/A | N/A | N/A | N/A | |
| F32-01 † | May 2014 | Fiurz Abad | 28°49.989′ N | 052°29.551′ E | Rice soil | N/A | N/A | N/A | N/A | |
| F201-3 † | May 2014 | Fiurz Abad | 28°51.587′ N | 052°30.842′ E | Rice soil | N/A | N/A | N/A | N/A | |
| KC11 ** | November 2015 | Ramjard | 30°05.476′ N | 052°35.563′ E | Rice crown | KX228081 | MK455866 | OP321100 | MK455858 | |
| KC5 ** | August 2014 | Persepolis | 29°58.892′ N | 052°57.734′ E | Rice soil | MK454707 | MK455865 | OP321099 | MK455856 | |
| KCr09 ** | August 2014 | Ramjard | 30°05.901′ N | 052°35.482′ E | Rice root | MK454706 | MK455864 | OP321101 | MK455857 | |
| G112-2 ** | May 2014 | Kamfiruz | 30°11.911′ N | 052°27.777′ E | Rice soil | N/A | N/A | N/A | N/A | |
| K101-4 ** | May 2014 | Kamfiruz | 30°11.845′ N | 052°27.787′ E | Pond water | N/A | N/A | N/A | N/A | |
| Globisporangium izadpanahii sp. nov. | ||||||||||
| K330-7 ‡ | November 2015 | Firuz Abad | 28°49.989′ N | 052°29.551′ E | Soil | MK454537 | MK455869 | OP321103 | MK455859 | |
| KGr1 | November 2015 | Kamfiruz | 29°58.823′ N | 052°53.651′ E | Rice crown | MK454535 | MK455867 | OP321105 | MK455861 | |
| KB14 | November 2015 | Kamfiruz | 30°19.236′ N | 052°16.560′ E | Pond water | MK454536 | MK455868 | OP321104 | MK455860 | |
| Rfa01 | November 2015 | Ramjard | 30°06.139′ N | 052°26.892′ E | Soil | N/A | N/A | N/A | N/A | |
| KHa3 | November 2015 | Kamfiruz | 30°18.134′ N | 052°17.767′ E | Rice root | N/A | N/A | N/A | N/A | |
| Species | Isolate Code | Pathogenicity on Rice | Symptom | |||||
|---|---|---|---|---|---|---|---|---|
| Post-Emergence Damping Off (%) | Pre-Emergence Damping Off (%) | Seed Rot (%) | Stunting (%) | No Growth (%) | Host Tissue Colonization * | |||
| Pythium banihashemianum sp. nov. | ||||||||
| 068B1 ** | + | 80 | 70 | 80 | 0 | 60 | + | |
| Fk21 ** | + | 70 | 60 | 90 | 0 | 70 | + | |
| Th641 ** | + | 90 | 60 | 40 | 0 | 50 | + | |
| KC11 † | + | 70 | 90 | 80 | 0 | 80 | + | |
| KC5 † | + | 80 | 60 | 60 | 0 | 70 | + | |
| KCr09 † | + | 90 | 50 | 70 | 0 | 50 | + | |
| Globisporangium izadpanahii sp. nov. | ||||||||
| K330-7 | − | 0 | 0 | 0 | 0 | 0 | − | |
| KB14 | − | 0 | 0 | 0 | 0 | 0 | − | |
| KGr1 | − | 0 | 0 | 0 | 0 | 0 | − | |
| Character | G. izadpanahii | G. coniferarum | G. nagaii | P. banihashemianum (Morphotype I: MT1, Morphotype II: MT2) | P. plurisporium | P. afertile | P. kashmirense |
|---|---|---|---|---|---|---|---|
| Cardinal Temperatures (°C) | 5; 35; 40 | 15; 30; 40 | 9; 28; 35 | MT1:10; 35; 40 MT2:5; 30; 40 | 15; 35; 40 | 5; 25; 30 | 5; 25; 35 |
| Daily Growth Rate at 25 °C (mm) | 7 | 6 | 25 | MT1:10 MT2:7 | 10 | 18 | 15 |
| Colony Pattern on CMA | Radial | Radial | No data | MT1; Radial MT2: Uniform | Radial | Compact colony without aerial mycelium | No data |
| Hyphae (µm) | 4.3 | 3.1–7.3 | 4 | MT1:3.1 MT2:3.5 | 8 | 6.6 | 5–6 |
| Chlamydospore | − | (+), (sub)globose, ovoid | − | − | − | + | − |
| Sporangium or Hyphal Swelling Production (µm) | (+) 13.2 | (+) 16.3–17.6 | (+) | (+) Variable | (+) Variable | (+) Variable | (+) Variable |
| Sporangium or Hyphal Swelling Shape | Globose | Ellipsoid, globose, ovoid, with pedicel | Ovoid, pyriform | MT1: filamentous, inflated; MT2: Filamentous, slightly inflated | Filamentous, inflated | Strictly filamentous | Filamentous, inflated, contiguous |
| Sporangium or Hyphal Swelling Position | Terminal or intercalary | Mostly terminal | Terminal | − | − | − | − |
| Sporangium Proliferation | − | − | + | − | − | − | − |
| Zoospore Production | − | + | + | + | + | + | + |
| Homothallic/Heterothallic | Homothallic | Homothallic | Homothallic | Homothallic | Homothallic | No sexual structure | Homothallic |
| Oogonium Ornamentation | Smooth with a papillae | Smooth | Smooth | Smooth with 2 papilla | Smooth | No sexual structure | Smooth |
| Oogonium Shape and Dimensions (µm) | Globose, 63 | Globose, ovoid, ellipsoid, 25.9–26.7 | Globose, sometimes irregular, 14–22 | MT1: Ovoid, amorphous, 33.3; MT2: Globose, 38.3 | Globose to obpyriform, 23–35 | − | Globose, 16.38 |
| Antheridium Shape | Crook-necked, elongated, clavate | Clavate to no specific shape | Clavate | MT1 & MT2: Clavate, crook-necked | Crook-necked | − | Coiled around oogonium |
| Antheridium Type and Number per Oogonium | Mostly monoclinous, 1 | Monoclinous and diclinous, paragynous, rarely hypogynous, 1–5 | Monoclinous, 1 (disappears after fertilization) | MT1: Monoclinous and diclinous, 4–8 MT2: mostly monoclinous, 1–4 | Monoclinous, and Diclinous, 2–12 | − | Diclinous1–8 |
| Oospore Type and Dimensions (µm) | Perfectly plerotic, 63 | Aplerotic and plerotic 21.3–23.2 | Aplerotic, 12–19 | MT1: Aplerotic, 32.5 MT2: Aplerotic, 32.4 | Aplerotic, 26.2–30 | − | Plerotic, 16.11 |
| Oospore Wall (µm) | 9.2 | 1.9–3.1 | 0.8 | MT1: 1.7 MT2:1.5 | 2.2–3 | − | 1.27 |
| Number of Oospore per Oogonium | 1 | 1 | 1 | MT1: 1–2 MT2: 1 | 1–6 | − | 1 |
Disclaimer/Publisher’s Note: The statements, opinions and data contained in all publications are solely those of the individual author(s) and contributor(s) and not of MDPI and/or the editor(s). MDPI and/or the editor(s) disclaim responsibility for any injury to people or property resulting from any ideas, methods, instructions or products referred to in the content. |
© 2024 by the authors. Licensee MDPI, Basel, Switzerland. This article is an open access article distributed under the terms and conditions of the Creative Commons Attribution (CC BY) license (https://creativecommons.org/licenses/by/4.0/).
Share and Cite
Salmaninezhad, F.; Mostowfizadeh-Ghalamfarsa, R.; Cacciola, S.O. Pythium banihashemianum sp. nov. and Globisporangium izadpanahii sp. nov.: Two New Oomycete Species from Rice Paddies in Iran. J. Fungi 2024, 10, 405. https://doi.org/10.3390/jof10060405
Salmaninezhad F, Mostowfizadeh-Ghalamfarsa R, Cacciola SO. Pythium banihashemianum sp. nov. and Globisporangium izadpanahii sp. nov.: Two New Oomycete Species from Rice Paddies in Iran. Journal of Fungi. 2024; 10(6):405. https://doi.org/10.3390/jof10060405
Chicago/Turabian StyleSalmaninezhad, Fatemeh, Reza Mostowfizadeh-Ghalamfarsa, and Santa Olga Cacciola. 2024. "Pythium banihashemianum sp. nov. and Globisporangium izadpanahii sp. nov.: Two New Oomycete Species from Rice Paddies in Iran" Journal of Fungi 10, no. 6: 405. https://doi.org/10.3390/jof10060405
APA StyleSalmaninezhad, F., Mostowfizadeh-Ghalamfarsa, R., & Cacciola, S. O. (2024). Pythium banihashemianum sp. nov. and Globisporangium izadpanahii sp. nov.: Two New Oomycete Species from Rice Paddies in Iran. Journal of Fungi, 10(6), 405. https://doi.org/10.3390/jof10060405

